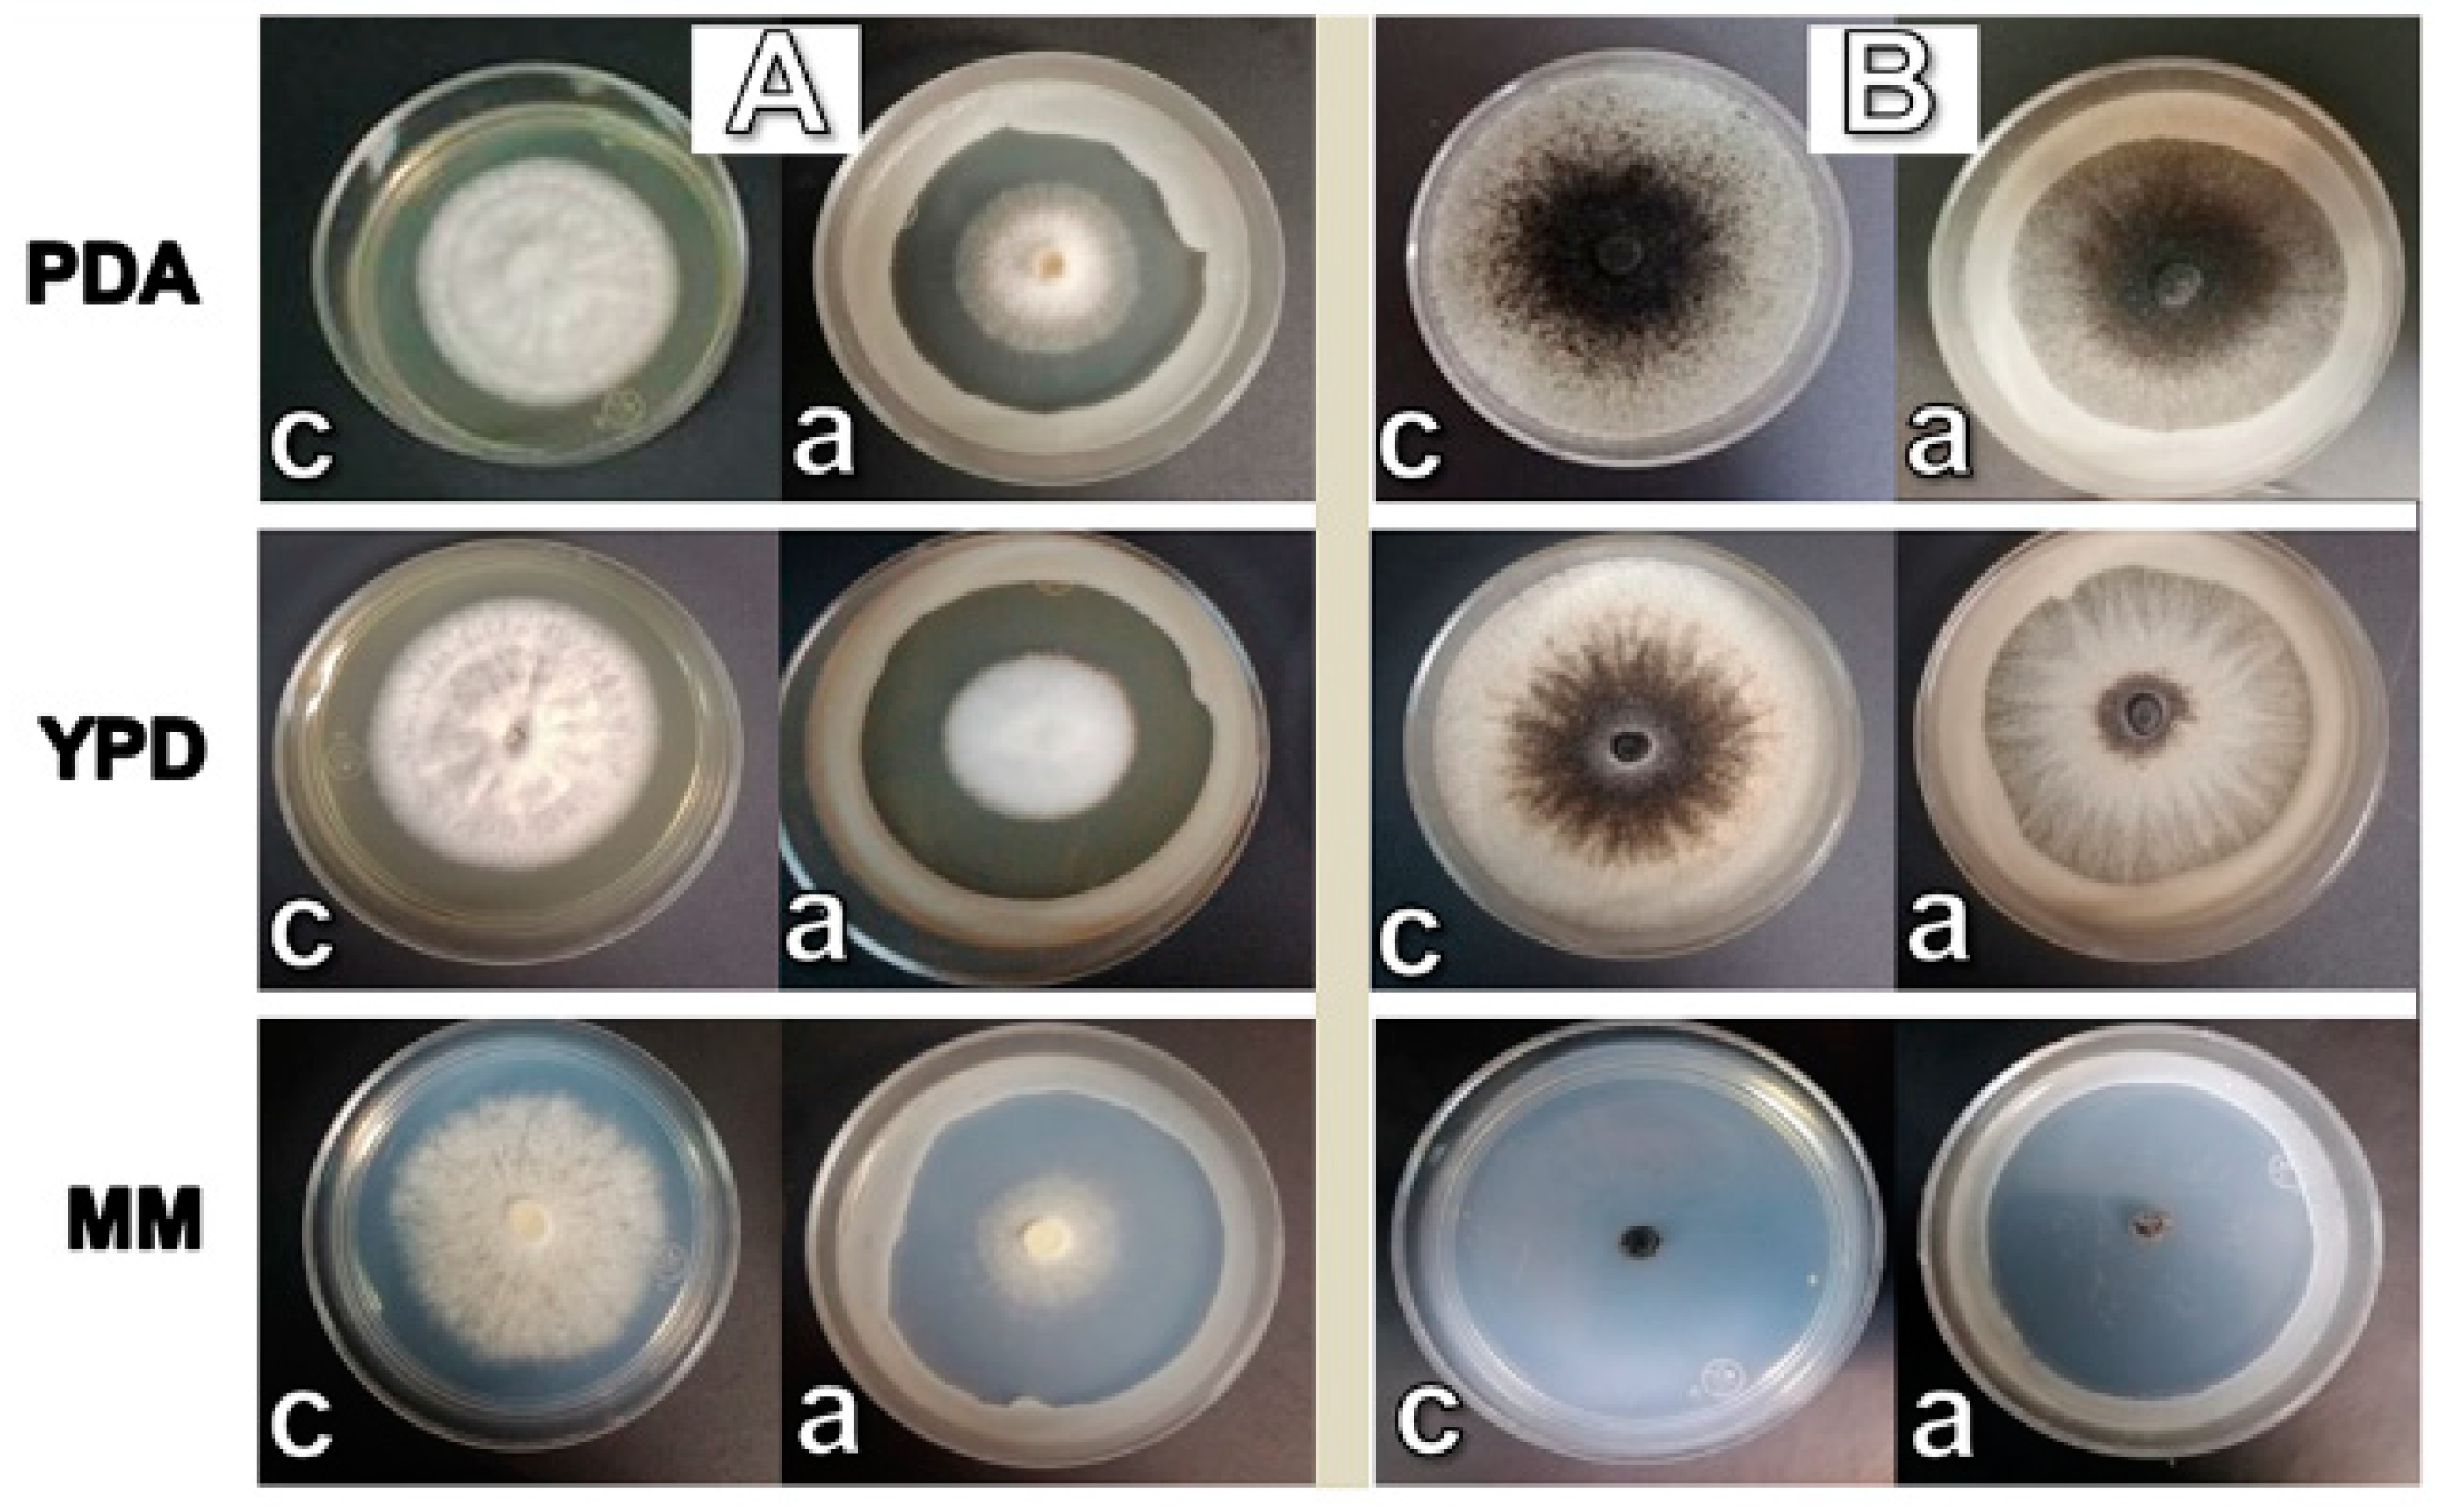
Agriculture 10 00325 g001 Agriculture 10 00325 g001

Biological Control of Thielaviopsis paradoxa and Colletotrichum gloeosporioides by the Extracellular Enzymes of Wickerhamomyces anomalus
Abstract
1. Introduction
2. Materials and Methods
2.1. Strains and Culture Conditions
2.2. Antagonism Tests Using W. anomalus Whole-Cells
2.3. Determination of the Influence of Chitinases and Glucanases as Part of the Antagonistic Effect. Enzymatic Production Systems
2.3.1. Analytical Methods. Enzyme Activity
2.3.2. Inducer Preparation for the Production of the Hydrolytic Enzymes
2.3.3. Production of Hydrolytic Enzymes. Evaluation of Expression Pattern
2.4. Evaluation of the Effect of Cell-Free Enzyme Extracts and Semi-Purified Glucanase on Conidia Germination of T. paradoxa and C. gloeosporioides
2.5. SDS-PAGE and Zymogram of the Semi-Purified Glucanase
2.6. Effect of the Crude Enzymatic Extract for the Protection of Post-Harvest Fruits
3. Results
3.1. W. anomalus Whole-Cells Inhibited the Growth of the Phytopathogenic Fungi
3.2. Effects of W. anomalus on Spore Germination of C. gloeosporioides and T. paradoxa in Liquid Media
3.3. Damage to the Phytopathogen Cell Wall Structures in Co-Culture with W. anomalus
3.4. Production of Hydrolytic Enzymes by W. anomalus
3.5. Inhibition of Spore Germination by the Enzymes Produced in YPD (Glucanase and Chitinase) and MM (Glucanase)
3.6. Electrophoretic Analysis and Zymogram of the Glucanase Produced by W. anomalus in MM
3.7. The Cell-Free Extract Is Effective for the Protection of Cacao Pods against T. paradoxa
4. Discussion
5. Conclusions
Author Contributions
Funding
Acknowledgments
Conflicts of Interest
References
- Dubey, N.K.; Singh, P.; Prakash, B.; Mishra, P.K. Plant Chemicals in Post-Harvest Technology for Management of Fungal, Mycotoxin and Insect Contamination of Food Commodities. In Biological Control. Progress in Biological Control; Mérillon, J., Ramawat, K., Eds.; Springer: Dordrecht, The Netherlands, 2012; Volume 12, pp. 195–208. [Google Scholar]
- Liu, J.; Sui, Y.; Wisniewski, M.; Droby, S.; Liu, Y. Utilization of antagonistic yeasts to manage postharvest fungal diseases of fruit. Int. J. Food Microbiol. 2013, 167, 153–160. [Google Scholar] [CrossRef] [PubMed]
- Heydari, A.; Pessarakli, M. A Review on Biological Control of Fungal Plant Pathogens Using Microbial Antagonists. J. Biol. Sci. 2010, 10, 273–290. [Google Scholar] [CrossRef]
- Sharma, R.; Singh, D.; Singh, R. Biological control of postharvest diseases of fruits and vegetables by microbial antagonists: A review. Biology 2009, 50, 205–221. [Google Scholar] [CrossRef]
- Yang, C.; Hamel, C.; Vujanovic, V.; Gan, Y. Fungicide: Modes of action and possible impact on non target microorganisms. ISRN Ecol. 2011, 2011, 1–8. [Google Scholar] [CrossRef]
- Pal, K.; Mcspadden, B. Biological control of plant pathogens. Plant Health Instr. 2006, 11, 1–25. [Google Scholar] [CrossRef]
- Droby, S.; Wisniewski, M.; Teixidó, N.; Spadaro, D.; Jijakli, M.H. The science, development, and commercialization of postharvest biocontrol products. Postharvest Biol. Technol. 2016, 122, 22–29. [Google Scholar] [CrossRef]
- Chaverri, P.; Branco-Rocha, F.; Jaklitsch, W.; Gazis, R.; Degenkolb, T.; Samuels, G.J. Systematics of the Trichoderma harzianum species complex and the re-identification of commercial biocontrol strains. Mycologia 2015, 107, 558–590. [Google Scholar] [CrossRef]
- Yien, T.; Yun, C. Chitinase and β-1,3-glucanase activities of Trichoderma harzianum in response towards pathogenic and non-pathogenic isolates: Early indications of compatibility in consortium. Biocatal. Agric. Biotechnol. 2015, 4, 109–113. [Google Scholar]
- Haïssam, J.M. Pichia anomala in biocontrol for apples: 20 years of fundamental research and practical applications. Anton Leeuwenhoek Int. J. Gen. Mol. Microbiol. 2011, 99, 93–105. [Google Scholar] [CrossRef]
- Freimoser, F.M.; Rueda-Mejia, M.P.; Tilocca, B.; Migheli, Q. Biocontrol yeasts: Mechanisms and applications. World J. Microbiol. Biotechnol. 2019, 35, 154–173. [Google Scholar] [CrossRef]
- Zhang, D.; Spadaro, D.; Garibaldi, A.; Gullino, M.L. Potential biocontrol activity of a strain of Pichia guilliermondii against grey mold of apples and its possible modes of action. Biology 2011, 57, 193–201. [Google Scholar] [CrossRef]
- Swiontek, B.M.; Jankiewicz, U.; Burkowska, A. Chitinolytic microorganisms and their possible application in environmental protection. Curr. Microbiol. 2014, 68, 71–81. [Google Scholar] [CrossRef] [PubMed]
- Hartl, L.; Zach, S.; Seidl-Seiboth, V. Fungal chitinases: Diversity, mechanistic properties and biotechnological potential. Appl. Microbiol. Biotechnol. 2012, 93, 533–543. [Google Scholar] [CrossRef] [PubMed]
- Diaz-Rincon, D.J.; Duque, I.; Osorio, E.; Rodriguez-Lopez, A.; Espejo-Mojica, A.; Parra-Giraldo, C.M.; Quevedo-Hidalgo, B. Production of recombinant Trichoderma reesei Cellobiohydrolase II in a new expression system based on Wickerhamomyces anomalus. Enzyme Res. 2017, 2017, 1–8. [Google Scholar] [CrossRef]
- Aloui, H.; Licciardello, F.; Khwaldia, K.; Hamdi, M.; Restuccia, C. Physical properties and antifungal activity of bioactive films containing Wickerhamomyces anomalus killer yeast and their application for preservation of oranges and control of postharvest green mold caused by Penicillium digitatum. Int. J. Food Microbiol. 2015, 200, 22–30. [Google Scholar] [CrossRef]
- Hashem, M.; Alamri, S.A.; Hesham, A.E.L.; Al-Qahtani, F.M.; Kilany, M. Biocontrol of apple blue mould by new yeast strains: Cryptococcus albidus KKUY0017 and Wickerhamomyces anomalus KKUY0051 and their mode of action. Biocontrol Sci. Technol. 2014, 24, 1137–1152. [Google Scholar] [CrossRef]
- Chi, M.; Li, G.; Liu, Y.; Liu, G.; Li, M.; Zhang, X.; Sun, Z.; Sui, Y.; Liu, J. Increase in antioxidant enzyme activity, stress tolerance and biocontrol efficacy of Pichia kudriavzevii with the transition from a yeast-like to biofilm morphology. Biology 2015, 90, 113–119. [Google Scholar] [CrossRef]
- Passoth, V.; Fredlund, E.; Druvefors, U.A.; Schnurer, J. Biotechnology, physiology and genetics of the yeast Pichia anomala. FEMS Yeast Res. 2006, 6, 3–13. [Google Scholar] [CrossRef]
- Fredlund, E.; Blank, L.; Schnu¨rer, J.; Sauer, U.; Passoth, V. Oxygen and glucose dependent regulation of central carbon metabolism in Pichia anomala. Appl. Environ. Microbiol. 2004, 70, 5905–5911. [Google Scholar] [CrossRef]
- Tayel, A.; El-tras, W.; Moussa, S. Antifungal action of Pichia anomala against aflatoxigenic Aspergillus flavus and its application as a feed supplement. J. Sci. Food Agric. 2013, 93, 3259–3263. [Google Scholar] [CrossRef]
- Zepeda, G.; Olicón-Hernández, D.R.; Martínez, C.; Guerra-Sánchez, G. Study of the action mode of Wickerhamomyces anomalus against Colletotrichum gloeosporioides. J. Agric. Sci. Technol. B 2016, 6, 341–349. [Google Scholar]
- Parafati, L.; Cirvilleri, G.; Restuccia, C.; Wisniewski, M. Potential role of exoglucanase genes (WaEXG1 and WaEXG2) in the biocontrol activity of Wickerhamomyces anomalus. Microbiol. Ecol. 2017, 73, 876–884. [Google Scholar] [CrossRef] [PubMed]
- Dean, R.; Van Kan, J.A.; Pretorius, Z.A.; Hammond-Kosack, K.E.; Di Pietro, A.; Spanu, P.D.; Foster, G.D. The Top 10 fungal pathogens in molecular plant pathology. Mol. Plant Pathol. 2012, 13, 414–430. [Google Scholar] [CrossRef]
- Aiello, D.; Carrieri, R.; Guarnaccia, V.; Vitale, A.; Lahoz, E.; Polizzi, G. Characterization and pathogenicity of Colletotrichum gloeosporioides and C. karstii causing preharvest disease on Citrus sinensis in Italy. J. Phytopathol. 2015, 163, 168–177. [Google Scholar] [CrossRef]
- Wijesinghe, C.J.; Wijeratnam, R.W.; Samarasekara, J.K.R.R.; Wijesundera, R.L.C. Biological control of Thielaviopsis paradoxa on pineapple by an isolate of Trichoderma asperellum. Biol. Control 2010, 53, 285–290. [Google Scholar] [CrossRef]
- Pardo-De la Hoz, C.J.; Calderón, C.; Rincón, A.M.; Cárdenas, M.; Danies, G.; López-Kleine, L.; Jiménez, P. Species from the Colletotrichum acutatum, Colletotrichum boninense and Colletotrichum gloeosporioides species complexes associated with tree tomato and mango crops in Colombia. Plant Pathol. 2016, 65, 227–237. [Google Scholar] [CrossRef]
- Sanchez, V.; Rebolledo, O.; Picaso, R.M.; Cardenas, E.; Cordova, J.; Gonzalez, O.; Samuels, G.J. In vitro antagonism of Thielaviopsis paradoxa by Trichoderma longibrachiatum. Mycopathologia 2007, 163, 49–58. [Google Scholar] [CrossRef]
- Felestrino, É.; Santiago, I.; Freitas, L.; Rosa, L.; Ribeiro, S.; Moreira, L. Plant growth promoting bacteria associated with Langsdorffia hypogaea-rhizosphere-host biological interface: A neglected model of bacterial prospection. Front. Microbiol. 2017, 8, 172–187. [Google Scholar] [CrossRef] [PubMed]
- Bhattacharya, S.; Das, A.; Samadder, S.; Rajan, S.S. Biosynthesis and characterization of a thermostable, alkali-tolerant chitinase from Bacillus pumilus JUBCH08 displaying antagonism against phytopathogenic Fusarium oxysporum. 3 Biotech 2016, 6, 87–95. [Google Scholar] [CrossRef] [PubMed]
- Ramada, M.; Lopes, F.; Ulhoa, C.; Silva, R. Optimized microplate beta-1,3-glucanase assay system for Trichoderma spp. screening. J. Microbiol. Methods 2010, 81, 6–10. [Google Scholar] [CrossRef]
- Miller, G.L. Use of Dinitrosalicylic Acid Reagent for Determination of Reducing Sugar. Anal. Chem. 1959, 31, 426–428. [Google Scholar] [CrossRef]
- Gubbins, P.O.; Anaissie, E.J. Antifungal Therapy. Clinical Mycology, 2nd ed.; Churchill Livingstone: London, UK, 2009; pp. 161–195. [Google Scholar]
- Murthy, N.S.; Bleakley, B.H. Simplified method of preparing colloidal chitin used for screening of chitinase-producing microorganisms. J. Microbiol. 2012, 10, 1–5. [Google Scholar]
- Laemmli, U. Cleavage of structural proteins during the assembly of the head of bacteriophage T4. Nature 1970, 227, 680–685. [Google Scholar] [CrossRef]
- Hong, S.; Song, Y.; Seo, S.; Kim, K.; Jung, W. Antifungal activity and expression patterns of extracellular chitinases and b-1,3-glucanase in Wickerhamomyces anomalus EG2 treated with chitin and glucan. Microb. Pathog. 2017, 110, 159–164. [Google Scholar] [CrossRef]
- Hong, S.; Song, Y.; Seo, S.; Kim, K.; Jung, W. Enzyme activity and expression pattern of intra-and extracellular chitinase and-1,3-glucanase of Wickerhamomyces anomalus EG2 using glycol chitin and glucan-containing high polymer complex. Int. J. Biol. Macromol. 2017, 105, 410–415. [Google Scholar] [CrossRef]
- Zajc, J.; Gostincar, C.; Cernosa, A.; Gunde-Cimerman, N. Stress-tolerant yeasts: Opportunistic pathogenicity versus biocontrol potential. Genes 2019, 10, 42. [Google Scholar] [CrossRef]
- Klein, M.N.; Kupper, K.C. Biofilm production by Aureobasidium pullulans improves biocontrol against sour rot in citrus. Food Microbiol. 2018, 69, 1–10. [Google Scholar] [CrossRef]
- Kamle, M.; Kumar, P. Colletotrichum gloeosporioides: Pathogen of anthracnose disease in Mango (Mangifera indica L.). In Current Trends in Plant Disease Diagnostics and Management Practices; Kumar, P., Gupta, V., Tiwari, A., Kamle, M., Eds.; Springer: Cham, Germany, 2016; Volume 1, pp. 207–2019. [Google Scholar]
- Xu, H.; Nobile, C.J.; Dongari-Bagtzoglou, A. Glucanase induces filamentation of the fungal pathogen Candida albicans. PLoS ONE 2013, 8, e63736. [Google Scholar] [CrossRef]
- Tay, S.T.; Lim, S.L.; Tan, H.W. Growth inhibition of Candida species by Wickerhamomyces anomalus mycocin and a lactone compound of Aureobasidium pullulans. BMC Complement. Altern. Med. 2014, 14, 439–450. [Google Scholar] [CrossRef]
- Cibelli, F.; Bevilacqua, A.; Raimondo, M.L.; Campaniello, D.; Carlucci, A.; Ciccarone, C.; Sinigaglia, M.; Corbo, M.R. Evaluation of fungal growth on olive-mill wastewaters treated at high temperature and by high-pressure homogenization. Front. Microbiol. 2017, 8, 2515–2524. [Google Scholar] [CrossRef]
- Coda, R.; Cassone, A.; Rizzello, C.G.; Nionelli, L.; Cardinali, G.; Gobbetti, M. Antifungal activity of Wickerhamomyces anomalus and Lactobacillus plantarum during sourdough fermentation: Identification of novel compounds and long-term effect during storage of wheat bread. Appl. Environ. Microbiol. 2011, 77, 3484–3492. [Google Scholar] [CrossRef]
- Druvefors, U.A.; Passoth, V.; Schnürer, J. Nutrient effects on biocontrol of Penicillium roqueforti by Pichia anomala J121 during airtight storage of wheat. Appl. Environ. Microbiol. 2005, 71, 1865–1869. [Google Scholar] [CrossRef]
- Platania, C.; Restuccia, C.; Muccilli, S.; Cirvilleri, G. Efficacy of killer yeasts in the biological control of Penicillium digitatum on Tarocco orange fruits (Citrus sinensis). Food Microbiol. 2012, 30, 219–225. [Google Scholar] [CrossRef]
- Frändberg, E.; Schnürer, J. Chitinolytic properties of Bacillus pabuli K1. J. Appl. Bacteriol. 1994, 76, 361–367. [Google Scholar] [CrossRef]
- Ambrico, A.; Trupo, M. Efficacy of cell free supernatant from Bacillus subtilis ET-1, an Iturin A producer strain, on biocontrol of green and gray mold. Postharvest Biol. Technol. 2017, 134, 5–10. [Google Scholar] [CrossRef]
- Jiang, L.; Jeong, J.C.; Lee, J. Potential of Pantoea dispersa as an effective biocontrol agent for black rot in sweet potato. Sci. Rep. 2019, 9, 16354–16367. [Google Scholar] [CrossRef]

© 2020 by the authors. Licensee MDPI, Basel, Switzerland. This article is an open access article distributed under the terms and conditions of the Creative Commons Attribution (CC BY) license (http://creativecommons.org/licenses/by/4.0/).
Share and Cite
Zepeda-Giraud, L.F.; Olicón-Hernández, D.R.; Pardo, J.P.; Villanueva, M.G.A.; Guerra-Sánchez, G. Biological Control of Thielaviopsis paradoxa and Colletotrichum gloeosporioides by the Extracellular Enzymes of Wickerhamomyces anomalus. Agriculture 2020, 10, 325. https://doi.org/10.3390/agriculture10080325
Zepeda-Giraud LF, Olicón-Hernández DR, Pardo JP, Villanueva MGA, Guerra-Sánchez G. Biological Control of Thielaviopsis paradoxa and Colletotrichum gloeosporioides by the Extracellular Enzymes of Wickerhamomyces anomalus. Agriculture. 2020; 10(8):325. https://doi.org/10.3390/agriculture10080325
Chicago/Turabian StyleZepeda-Giraud, Luis Fernando, Dario Rafael Olicón-Hernández, Juan Pablo Pardo, Minerva Georgina Araiza Villanueva, and Guadalupe Guerra-Sánchez. 2020. "Biological Control of Thielaviopsis paradoxa and Colletotrichum gloeosporioides by the Extracellular Enzymes of Wickerhamomyces anomalus" Agriculture 10, no. 8: 325. https://doi.org/10.3390/agriculture10080325
APA StyleZepeda-Giraud, L. F., Olicón-Hernández, D. R., Pardo, J. P., Villanueva, M. G. A., & Guerra-Sánchez, G. (2020). Biological Control of Thielaviopsis paradoxa and Colletotrichum gloeosporioides by the Extracellular Enzymes of Wickerhamomyces anomalus. Agriculture, 10(8), 325. https://doi.org/10.3390/agriculture10080325

